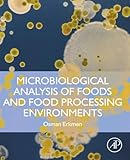
Amazon cover image

Microbiological Analysis of Foods and Food Processing Environments
Material type: TextLanguage: English Publication details: Academic Press Elsevier 2022ISBN:
TextLanguage: English Publication details: Academic Press Elsevier 2022ISBN: - 9780323916516
 eBooks
eBooks
| Item type | Current library | Home library | Status | Barcode | |
|---|---|---|---|---|---|
 eBooks
eBooks
|
Central Library | Central Library | Available | CL1717611 |
There are no comments on this title.
Log in to your account to post a comment.